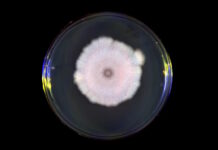
Не стоит верить всему, что говорят: дезинформацию впервые использовали вовсе не люди (видео)

26 июля, в воскресенье, температура воздуха в Украине ожидается высокой, осадки прогнозируются на большей части страны. Дневная температура воздуха в среднем по стране прогнозируется от +21 до +29 градусов.
Об этом сообщила главный метеоролог портала Оpogode.ua Наталья Диденко в Facebook.
По словам метеоролога, температура воздуха 26 июля, в воскресенье, ожидается высокой. Днем +21 +29 градусов, на юге до +33 градусов, на западе будет свежее.
26 июля в Украине ожидаются дожди, в западной части Украины дожди могут быть сильными, что может привести к повышению уровня воды в реках.
В западных, северных областях и Винницкой области ожидаются кратковременные дожди с грозами. В Карпатском регионе ожидаются значительные дожди, на остальной территории без осадков.
В Киеве в воскресенье вероятен дождь с грозой. Температура воздуха позволит брать минимум вещей на отдых, днем в столице ожидается +26 +29 градусов.